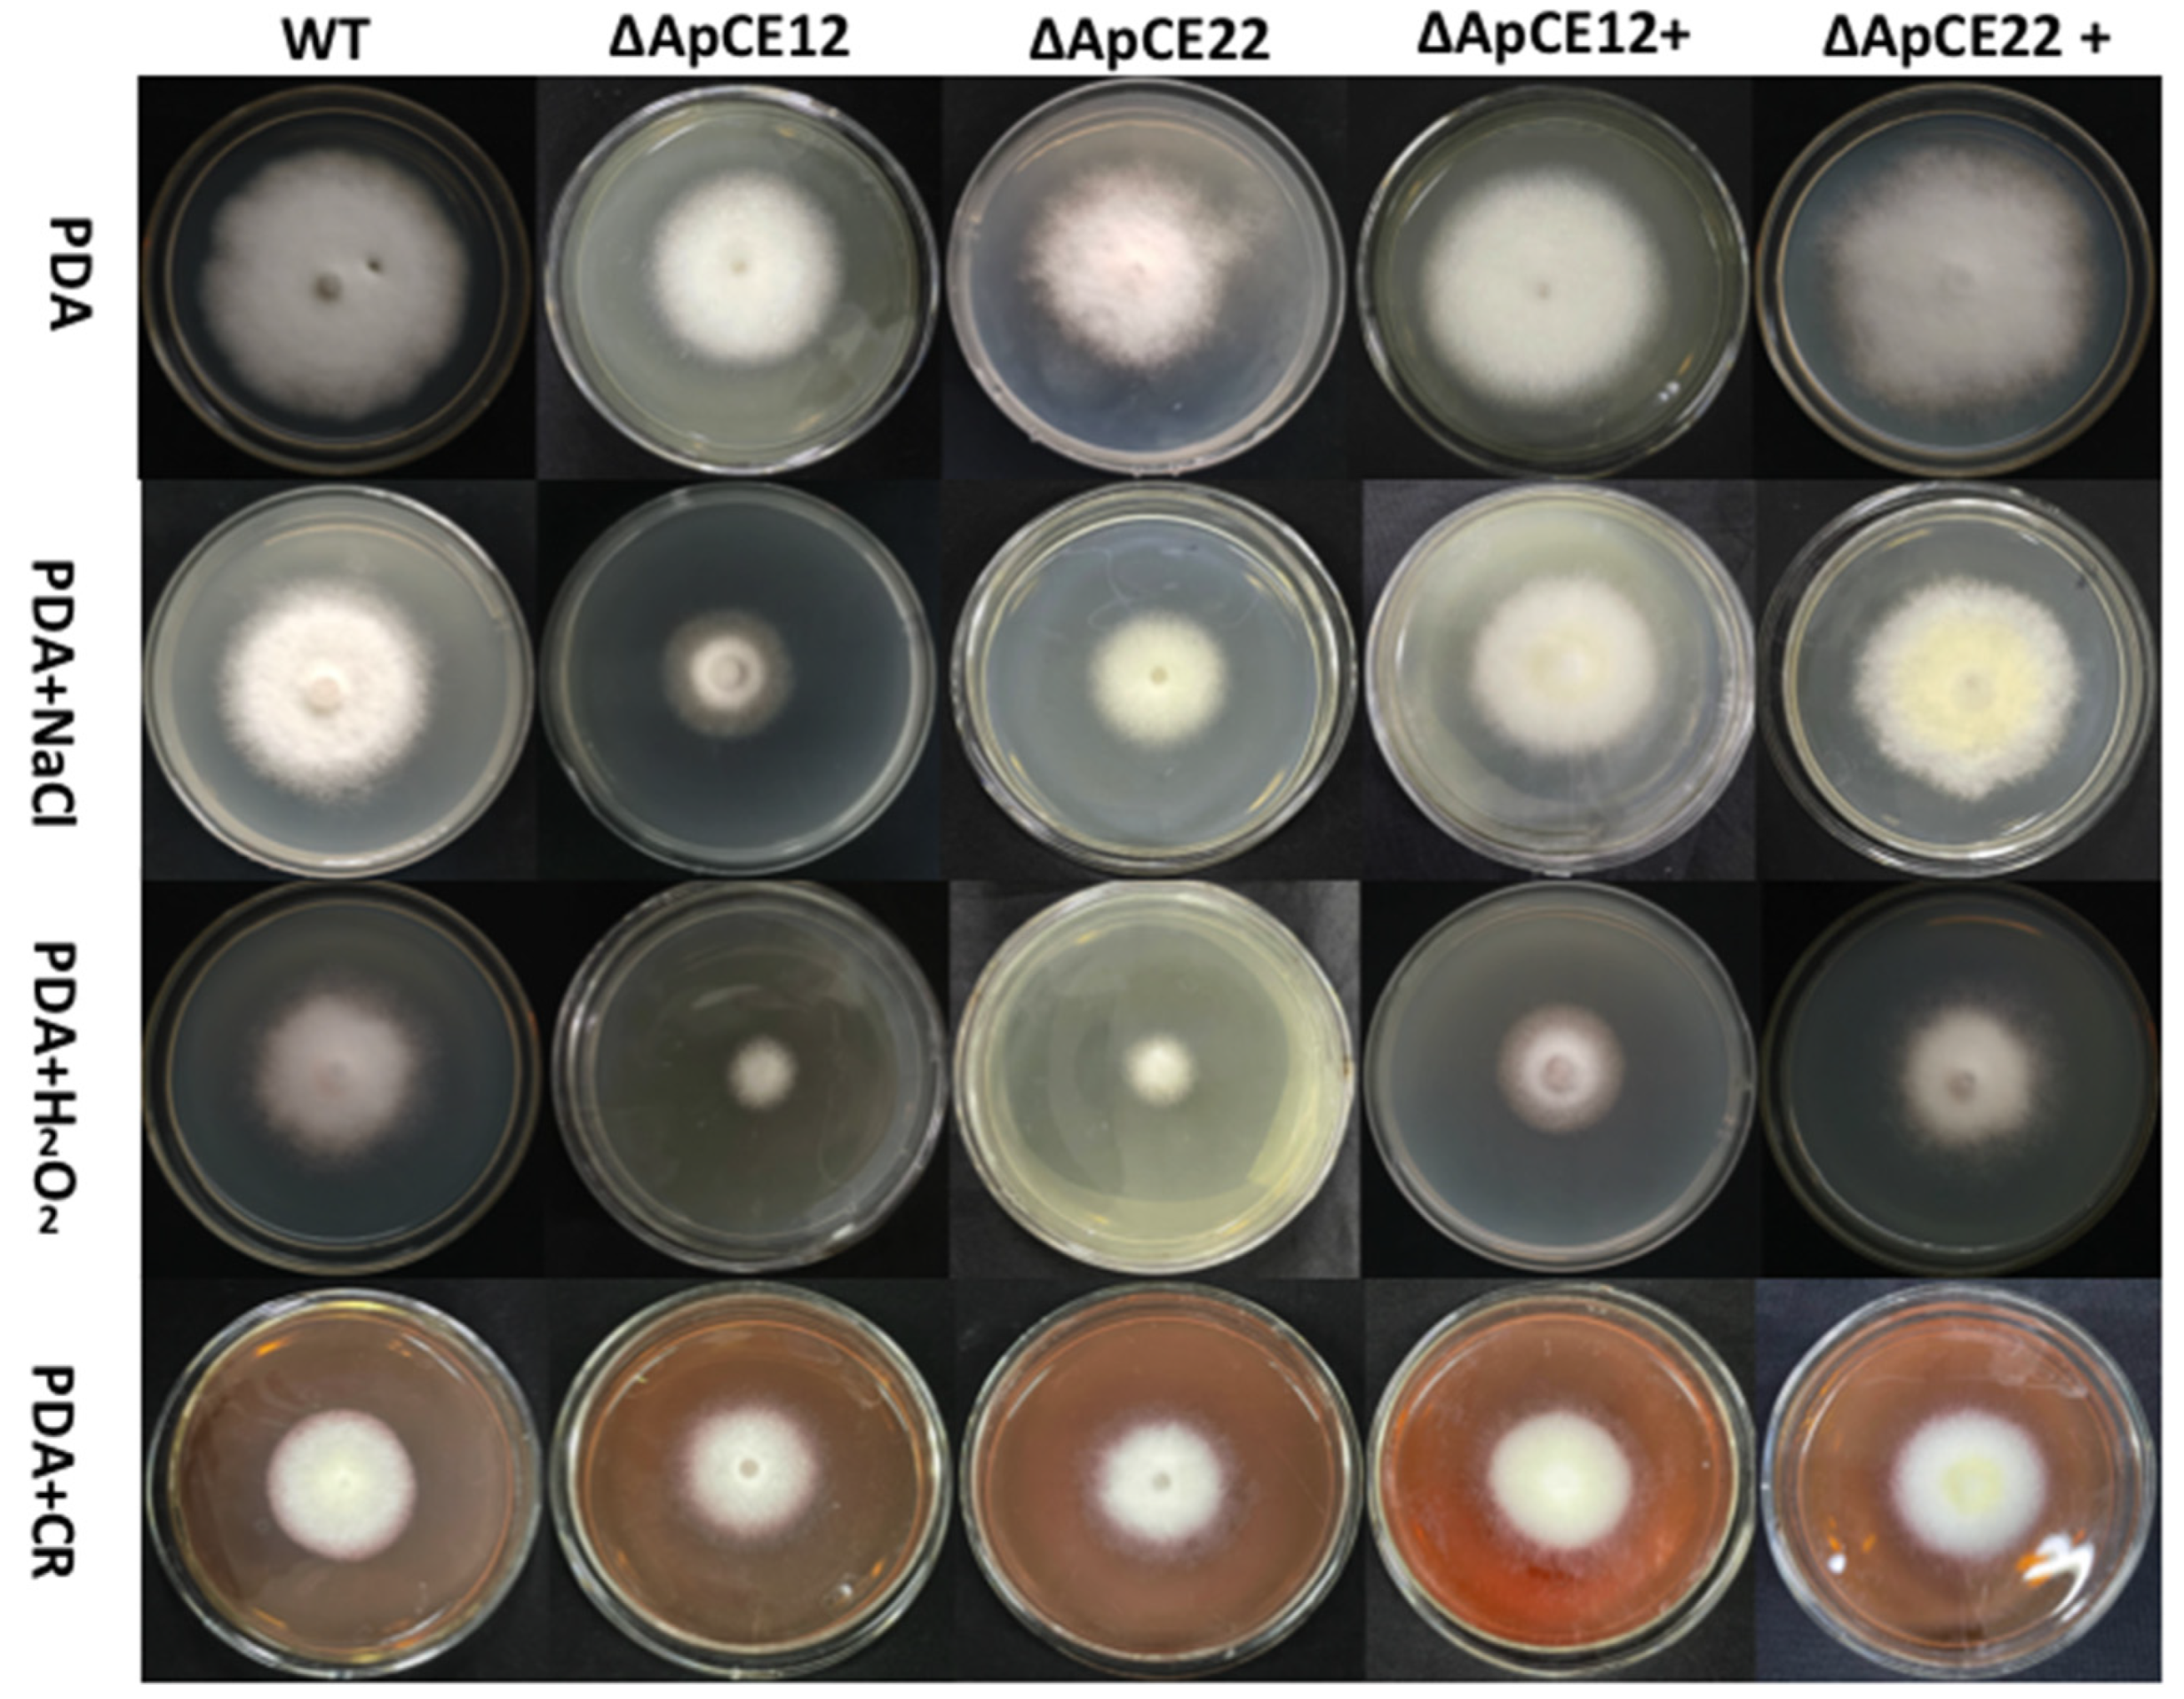
Biomolecules 12 01264 g011

Functional Identification of Arthrinium phaeospermum Effectors Related to Bambusa pervariabilis × Dendrocalamopsis grandis Shoot Blight
Abstract
:1. Introduction
2. Materials and Methods
2.1. Strains and Plants
2.2. Sample Collection and RNA Extraction
2.3. Library Construction and Sequencing
2.4. Data Quality Control and Alignment with the Reference Genome
2.5. Gene Expression Level and Differential Expression Analyses
2.6. GO and KEGG Enrichment Analysis of Differentially Expressed Genes in Pathogens and Hosts
2.7. Association Analysis between Pathogens and Hosts
2.8. Quantitative Verification of Differentially Expressed Genes
2.9. Screening and Validation of Effectors in A. Phaeospermum
2.10. Expression of Effectors in Tobacco Detected by RT–PCR
2.11. Gene Knockout and Genetic Transformation
2.12. Phenotypic Analysis and Pathogenicity Test of Mutant and Complementary Strains
3. Results
3.1. Sequencing Data Quality Detection and Alignment to the Reference Genome
3.2. Dual-seq Differentially Expressed Gene Analysis
3.3. GO and KEGG Enrichment Analyses of Differentially Expressed Genes
3.4. Dual RNA-seq Interaction Gene Annotation
3.5. Prediction of Effectors of A. Phaeospermum
3.6. qRT–PCR Verification of Differentially Expressed Genes in Dual-seq Sequencing
3.7. Tobacco Transient Expression Identification Effector
3.8. Results of Gene Knockout and Knockout Complementation
3.8.1. Amplification of the Fusion Fragment and Genetic Transformation of Mutant and Complementary Strains
3.8.2. Phenotypic Analysis of Transformants
3.8.3. Pathogenicity Test of Transformants
4. Discussion
5. Conclusions
Supplementary Materials
Author Contributions
Funding
Institutional Review Board Statement
Informed Consent Statement
Data Availability Statement
Conflicts of Interest
References
- Yang, X.J.; Zhang, L.C.; Li, Y.W.; Wang, Y.W. Research progress of plant pathogenic effectors. Chin. Sci. Life Sci. 2020, 50, 227. [Google Scholar]
- Zhang, J.; Dong, S.M.; Wang, W.; Zhao, J.H.; Chen, X.W.; Guo, H.S. Plant immunity research and green prevention and control of disease and insect resistance: Progress, opportunities and challenges. Chin. Sci. Life Sci. 2019, 11, 1479–1507. [Google Scholar]
- Ranf, S. Sensing of molecular patterns through cell surface immune receptors. Curr. Opin. Plant Biol. 2017, 38, 68–77. [Google Scholar] [CrossRef] [PubMed]
- Dangl, J.L.; Horvath, D.M.; Staskawicz, B.J. Pivoting the plant immune system from dissection to deployment. Science 2013, 341, 746–751. [Google Scholar] [CrossRef]
- Jones, J.D.G.; Dang, J.L. The Plant immune system. Nature 2006, 444, 323–329. [Google Scholar] [CrossRef]
- Gust, A.A.; Willmann, R.; Desaki, Y.; Grabherr, H.M.; Murnberger, T. Plant LysM proteins: Modules mediating symbiosis and immunity. Trend Plant Sci. 2012, 17, 495–502. [Google Scholar] [CrossRef]
- Kombrink, A.; Sanchez-Vallet, A.; Thomma, B.P.H.J. The role of chitin detection in plant-pathogen interactions. Microbes Infect. 2011, 13, 1168–1176. [Google Scholar] [CrossRef]
- Miya, A.; Albert, P.; Shinya, T.; Desaki, Y.; Ichimura, K.; Shirasu, K.; Narusaka, Y.; Kawakami, N.; Kaku, H.; Shibuya, N. CERK1, a LysM receptor kinase, is essential for chitin elicitor signaling in Arabidopsis. Proc. Natl. Acad. Sci. USA 2007, 104, 19613–19618. [Google Scholar] [CrossRef]
- Shimizu, T.; Nakano, T.; Takamizawa, D.; Desaki, Y.; Ishii-Minami, N.; Nishizawa, Y.; Minami, E.; Okada, K.; Yamane, H.; Kaku, H. Two LysM receptor molecules, CEBiP and OsCERK1, cooperatively regulate chitin elicitor signaling in rice. Plant J. 2010, 64, 204–214. [Google Scholar] [CrossRef]
- Bozsoki, Z.; Cheng, J.; Feng, F.; Gysel, K.; Vinther, M.; Andersen, K.R.; Oldroyd, G.; Blaise, M.; Radutoiu, S.; Stougaard, J. Receptor-mediated chitin perception in legume roots is functionally separable from Nod factor perception. Proc. Natl. Acad. Sci. USA 2017, 114, E8118–E8127. [Google Scholar] [CrossRef]
- Rafiqi, M.; Jeffrey G Ellis, J.G.; Ludowici, V.A.; Hardham, A.R.; Dodds, P.N. Challenges and progress towards understanding the role of effectors in plant–fungal interactions. Curr. Opin. Plant Biol. 2012, 15, 477–482. [Google Scholar] [CrossRef] [PubMed]
- Ellis, J.G.; Rafiqi, M.; Gan, P.; Chakrabarti, A.; Dodds, P.N. Recent progress in discovery and functional analysis of effector proteins of fungal and oomycete plant pathogens. Curr. Opin. Plant Biol. 2009, 12, 399–405. [Google Scholar] [CrossRef] [PubMed]
- Mishra, N.C.; Tatum, E.L. Non-Mendelian inheritance of DNA-induced inositol independence in Neurospora. Proc. Natl. Acad. Sci. USA 1973, 70, 3875–3879. [Google Scholar] [CrossRef] [PubMed]
- Bull, J.H.; Wootton, J.C. Heavily methylated amplified DNA in transformants of Neurospora crassa. Nature 1984, 310, 701–704. [Google Scholar] [CrossRef]
- Zhang, X.X.; Zhao, M.; Jiang, J.; Yang, L.L.; Yang, Y.W.; Yang, S.S.; Walcott, R.; Qiu, D.W.; Zhao, T.C. Identification and Functional Analysis of AopN, an Acidovorax Citrulli Effector that Induces Programmed Cell Death in Plants. Int. J. Mol. Sci. 2020, 21, 6050. [Google Scholar] [CrossRef]
- Xu, Q.; Tang, C.L.; Wang, X.D.; Sun, S.T.; Zhao, J.R.; Kang, Z.S.; Wang, X.J. An effector protein of the wheat stripe rust fungus targets chloroplasts and suppresses chloroplast function. Nat. Commun. 2019, 10, 5571–5583. [Google Scholar] [CrossRef]
- Djamei, A.; Schipper, K.; Rabe, F.; Ghosh, A.; Vincon, V.; Kahnt, J.; Osorio, S.; Tohge, T.; Fernie, A.R.; Feussner, I. Metabolic priming by a secreted fungal effector. Nature 2011, 478, 395–398. [Google Scholar] [CrossRef]
- Westermann, A.J.; Gorski, S.A.; Vogel, J.J. Dual RNA-seq of pathogen and host. Nat. Rev. Microbiol. 2012, 10, 618–630. [Google Scholar] [CrossRef]
- Guptaa, M.; Sharmaa, G.J.; Saxenaa, D.; Budhwar, R.; Vasudevan, M.; Gupta, V.; Gupta, A.; Gupta, R.; Chandran, D. Dual RNA-Seq analysis of Medicago truncatula and the pea powdery mildew Erysiphe pisi uncovers distinct host transcriptional signatures during incompatible and compatible interactions and pathogen effector candidates. Genomics 2020, 112, 2130–2145. [Google Scholar] [CrossRef]
- Liao, Z.X.; Ni, Z.; Wei, X.L.; Chen, L.; Li, J.Y.; Yu, Y.H.; Jiang, W.; Jiang, B.L.; He, Y.Q.; Huang, S. Dual RNA-seq of Xanthomonas oryzae pv. oryzicola infecting rice reveals novel insights into bacterial-plant interaction. PLoS ONE 2019, 14, e0215039. [Google Scholar] [CrossRef]
- Musungu, B.; Bhatnagar, D.; Quiniou, S.; Brown, R.L.; Payne, G.A.; O’Brian, G.; Fakhoury, A.M.; Geisler, M. Use of Dual RNA-seq for Systems Biology Analysis of Zea mays and Aspergillus flavus Interaction. Front. Microbiol. 2020, 11, 853. [Google Scholar] [CrossRef]
- Gétaz, M.; Puławska, J.; Smits, T.H.M.; Pothier, J.F. Pothier Host–Pathogen Interactions between Xanthomonas fragariae and Its Host Fragaria × ananassa Investigated with a Dual RNA-Seq Analysis. Microorganisms 2020, 8, 1253. [Google Scholar] [CrossRef]
- Andriy Kovalchuk, A.; Zhen Zeng, Z.; Rajendra, P.G.; Kivimäenpää, M.; Raffaello, T.; Liu, M.X.; Mukrimin, M.; Kasanen, R.; Sun, H.; Julkunen-Tiitto, R.; et al. Dual RNA-seq analysis provides new insights into interactions between Norway spruce and necrotrophic pathogen Heterobasidion annosum s.l. BMC Plant Biol. 2019, 19, 2. [Google Scholar] [CrossRef]
- Guo, L.; Zhao, G.; Xu, J.R.; Kistler, H.C.; Gao, L.; Ma, L.J. Compartmentalized gene regulatory network of the pathogenic fungus Fusarium graminearum. New Phytol. 2016, 211, 527. [Google Scholar] [CrossRef]
- Banf, M.; Rhee, S.Y. Enhancing gene regulatory network inference through data integration with markov random fields. Sci. Rep. 2017, 7, 41174. [Google Scholar] [CrossRef] [PubMed]
- Zhu, T.H.; Huang, Z.C.; Gao, Q.Z. Research on survey and space distribution of Bambusa ervariabilis × Dendrocalamopsis daii blight. J. Sichuan For. Sci. Technol. 2009, 30, 29–31, 37. [Google Scholar]
- Li, S.J.; Zhu, T.H.; Zhu, H.M.Y. Purification of protein AP-toxin from Arthrinium phaeospermum causing blight in Bambusa pervariabilis × Dendrocalamopsis grandis and its metabolic effects on four bamboo varieties. Phytopathology 2013, 103, 135–145. [Google Scholar] [PubMed]
- Li, S.J.; Zhu, T.H. Purification of the toxin protein PC from Arthrinium phaeospermum and its effect on the defence enzymes of Bambusa pervariabilis × Dendrocalamopsis grandis varieties. For. Pathol. 2014, 44, 96–106. [Google Scholar]
- Li, S.; Qiao, T.; Han, S.; Zhu, T.; Che, G. Effects of Protein Toxin from Arthrinium phaeospermum on Biophysical Characteristic and Respiration of Bambusa pervariabilis × Dendrocalamopsis grandis Mitochondria. Sci. Silyae Sin. 2014, 8, 119–125. [Google Scholar]
- Li, S.J.; Zhu, T.H. Binding site of toxic protein from Arthrinium phaeospermum on plasmalemma of hybrid bamboo. J. Zhejiang Univ. Agric. Life Sci. Ed. 2014, 4, 355–361. [Google Scholar] [CrossRef]
- Peng, Q.; Fang, X.M.; Zong, X.Z.; He, Q.Q.; Zhu, T.H.; Han, S.; Li, S.J. Comparative transcriptome analysis of Bambusa pervariabilis × Dendrocalamopsis grandis against Arthrinium phaeospermum under protein AP-toxin induction. Gene 2019, 725, 144160. [Google Scholar] [CrossRef] [PubMed]
- Li, S.J.; Fang, X.M.; Han, S.; Zhu, T.H.; Zhu, H.M.Y. Differential Proteome Analysis of Hybrid Bamboo (Bambusa pervariabilis × Dendrocalamopsis grandis) Under Fungal Stress (Arthrinium phaeospermum). Sci. Rep. 2019, 9, 18681. [Google Scholar] [CrossRef]
- He, Q.Q.; Fang, X.M.; Zhu, T.H.; Han, S.; Zhu, H.M.Y.; Li, S.J. Differential Proteomics Based on TMT and PRM Reveal the Resistance Response of Bambusa pervariabilis × Dendrocalamopisis grandis Induced by AP-Toxin. Metabolites 2019, 9, 166. [Google Scholar] [CrossRef]
- Westermann, A.J.; Barquist, L.; Vogel, J. Resolving host-pathogen interactions by dual RNA-seq. PLoS Pathog. 2017, 13, e1006033. [Google Scholar] [CrossRef]
- Daehwan, K.; Ben, L.; Salzberg, S.L. HISAT: A fast spliced aligner with low memory requirements. Nat. Methods 2015, 12, 357–360. [Google Scholar] [CrossRef] [Green Version]
- Grabherr, M.G.; Haas, B.J.; Yassour, M. Full-length transcriptome assembly from RNA-Seq data without a reference genome. Nat. Biotechnol. 2011, 29, 644–652. [Google Scholar]
- Trapnell, C.; Williams, B.A.; Pertea, G. Transcript assembly and quantification by RNA-Seq reveals unannotated transcripts and isoform switching during cell differentiation. Nat. Biotech. 2010, 28, 511–515. [Google Scholar]
- Young, M.D.; Wakefield, M.J.; Smyth, G.K.; Oshlack, A. Gene ontology analysis for RNA-seq: Accounting for selection bias. Genome Biol. 2010, 11, R14. [Google Scholar] [CrossRef]
- Mao, X.Z.; Cai, T.; Olyarchuk, J.G.; Wei, L.P. Automated genome annotation and pathway identification using the KEGG Orthology (KO) as a controlled vocabulary. Bioinformatics 2005, 21, 3787–3797. [Google Scholar] [CrossRef]
- Kim, K.H.; Kang, Y.J.; Kim, D.H.; Yoon, M.Y.; Moon, J.K.; Kim, M.Y.; Van, K.; Lee, S.H. RNA-Seq analysis of a soybean near-isogenic line carrying bacterial leaf pustule-resistant and -susceptible alleles. DNA Res. 2011, 18, 483–497. [Google Scholar] [CrossRef]
- Urban, M.; Cuzick, A.; Seager, J.; Wood, V.; Rutherford, K.; Venkatesh, S.Y.; De Silva, N.; Martinez, M.C.; Pedro, H.; Yates, A.D.; et al. PHI-base: The pathogen-host interactions database. Nucleic Acids Res. 2019, 1, D613–D620. [Google Scholar] [CrossRef]
- Liu, B.; Zheng, D.D.; Qi, J.; Chen, L.H.; Yang, J. VFDB 2019: A comparative pathogenomic platform with an interactive web interface. Nucleic Acids Res. 2019, 1, D687–D692. [Google Scholar] [CrossRef] [PubMed]
- Szklarczky, D.; Gable, A.L.; Lyon, D.; Junge, A.; Wyder, S.; Huerta-Cepas, J. STRING v11: Protein–protein association networks with increased coverage, supporting functional discovery in genome-wide experimental datasets. Nucleic Acids Res. 2018, 1, D607–D613. [Google Scholar] [CrossRef] [PubMed]
- Ammari, M.G.; Gresham, C.R.; McCarthy, F.M.; Nanduri, B. HPIDB 2.0: A curated database for host–pathogen interactions. Database 2016, 2016, baw103. [Google Scholar] [CrossRef]
- Livak, K.J.; Schmittgen, T.D. Analysis of relative gene expression data usingreal-time quantitative PCR and the 2−ΔΔCt method. Methods 2001, 25, 402–408. [Google Scholar] [CrossRef]
- Emanuelsson, O.; Brunak, S.; von Heijne, G.; Nielsen, H. Locating proteins in the cell using TargetP, SignalP and related tools. Nat. Protoc. 2007, 2, 953–971. [Google Scholar]
- Krogh, A.; Larsson, B.; Von Heijne, G.; Sonnhammer, E.L.L. Predicting transmembrane protein topology with a hidden Markov model: Application to complete genomes. J. Mol. Biol. 2001, 305, 567–580. [Google Scholar] [CrossRef]
- Tennant, J.R. Evaluation of the trypan blue technique for determination of cell viability. Transplantation 1964, 2, 685–694. [Google Scholar]
- Goswami, R.S. Targeted gene replacement in fungi using a Split-Marker approach. In Plant Fungal Pathogens; Methods in Molecular Biology; Humana Press: Totowa, NJ, USA, 2011; pp. 255–269. [Google Scholar]
- Fang, X.M.; Yan, Y.; Guan, M.M.; Han, S.; Qiao, T.M.; Lin, T.T.; Zhu, T.H.; Li, S.J. Comparative Transcriptomics and Gene Knockout Reveal Virulence Factors of Arthrinium phaeospermum in Bambusa Pervariabilis Dendrocalamopsis Grandis. J. Fungi 2021, 7, 1001. [Google Scholar] [CrossRef]
- Luo, F.Y.; Fang, X.M.; Liu, H.; Zhu, T.H.; Han, S.; Peng, Q.; Li, S.J. Differential transcriptome analysis and identification of genes related to resistance to blight in three varieties of Bambusa pervariabilis Dendrocalamopsis grandis. PeerJ 2021, 9, e12301. [Google Scholar]
- Yao, Z.P.; Chen, Q.J.; Chen, D.; Zhan, L.L.; Zeng, K.; Gu, A.X.; Zhou, J.; Zhang, Y.; Zhu, Y.F.; Gao, W.W.; et al. The susceptibility of sea-island cotton recombinant inbred lines to Fusarium oxysporum f. sp. vasinfectum infection is characterized by altered expression of long noncoding RNAs. Sci. Rep. 2019, 9, 2894. [Google Scholar] [CrossRef] [PubMed]
- Su, X.; Lu, G.; Guo, H.; Zhang, K.; Li, X.; Cheng, H. The dynamic transcriptome and metabolomics profiling in Verticillium dahliae inoculated Arabidopsis thaliana. Sci. Rep. 2018, 8, 15404. [Google Scholar] [PubMed]
- Qiao, F.F.; Yang, X.W.; Xu, F.D.; Huang, Y.; Zhang, J.M.; Song, M.; Zhou, S.M.; Zhang, M.; He, D.X. TMT-based quantitative proteomic analysis reveals defense mechanism of wheat against the crown rot pathogen Fusarium pseudograminearum. BMC Plant Biol. 2021, 21, 82. [Google Scholar] [CrossRef]
- Gao, X.Q.; Kevin, L.; Cox, J.; He, P. Functions of Calcium-Dependent Protein Kinases in Plant Innate Immunity. Plants 2014, 3, 160–176. [Google Scholar] [CrossRef]
- Kim, M.C.; Panstruga, R.; Elliott, C.; Muller, J.; Devoto, A.; Yoon, H.W.; Park, H.C.; Cho, M.J.; Schulze-Lefert, P. Calmodulin interacts with MLO protein to regulate defence against mildew in barley. Nature 2002, 416, 447–451. [Google Scholar]
- Overmyer, K.; Brosche, M.; Kangasjarvi, J. Reactive oxygen species and hormonal control of cell death. Trends Plant Sci. 2003, 8, 335–342. [Google Scholar]
- Miguel, A.T.; Jeffery, L.D. Functions of the respiratory burst oxidase in biotic interactions, abiotic stress and development. Curr. Opin. Plant Biol. 2005, 8, 397–403. [Google Scholar] [CrossRef]
- Ciardi, J.A. Response to Xanthomonas campestris pv. vesicatoria in tomato involves regulation of ethylene receptor gene expression. Plant Physiol. 2000, 123, 81–92. [Google Scholar]
- Bent, A.F. Disease development in ethylene-insensitive Arabidopsis thaliana infected with virulent and avirulent Pseudomonas and Xanthomonas pathogens. Mol. Plant–Microbe Interact. 1992, 5, 372–378. [Google Scholar]
- Wei, Y.X.; Zhu, B.B.; Liu, W.; Cheng, X.; Lin, D.Z.; He, C.Z.; Shi, H.T. Heat shock protein 90 co-chaperone modules fine-tune the antagonistic interaction between salicylic acid and auxin biosynthesis in cassava. Cell Rep. 2021, 34, 108717. [Google Scholar] [CrossRef]
- Thara, K.V.; Tang, X.; Gu, Y.Q.; Martin, G.B.; Zhou, J.M. Pseudomonas syringae pv. tomato induces the expression of tomato EREBP-like genes Pti4 and Pti5 independent of ethylene, salicylate and jasmonate. Plant J. 1999, 20, 475–484. [Google Scholar] [CrossRef] [PubMed]
- Gu, Y.Q.; Wildermuth, M.C.; Chakravarthy, S.; Loh, Y.T.; Yang, C.M.; He, X.H.; Han, Y.; Gregory, B.M. Tomato Transcription Factors Pti4, Pti5, and Pti6 Activate Defense Responses When Expressed in Arabidopsis. Plant Cell Vol. 2002, 14, 817–831. [Google Scholar] [CrossRef] [PubMed]
- Balagué, C.; Lin, B.Q.; Alconb, C.; Flottes, G.; Malmström, S.; Köhler, C.; Neuhaus, G.; Pelletier, G.; Gaymard, F.; Robya, D. HLM1, an Essential Signaling Component in the Hypersensitive Response, Is a Member of the Cyclic Nucleotide–Gated Channel Ion Channel Family. Plant Cell 2003, 15, 365–379. [Google Scholar] [CrossRef] [PubMed]
- Xu, Y.P.; Li, W.; Wang, J.P.; Cai, X.Z. Cyclic nucleotide gated channel gene family in tomato: Genome-wide identification and functional analyses in disease resistance. Front. Plant Sci. 2015, 6, 303. [Google Scholar] [CrossRef] [Green Version]
- Jonak, C.; Ökrész, L.; Bögre, L.; Hirt, H. Complexity, cross talk and integration of plant MAP kinase signalling. Curr. Opin. Plant Biol. 2002, 5, 415–424. [Google Scholar] [CrossRef]
- Asai, T.; Tena, G.; Plotnikova, J.; Willmann, M.R.; Chiu, W.L. MAP kinase signalling cascade in Arabidopsis innate immunity. Nature 2002, 415, 977–983. [Google Scholar] [CrossRef]
- Zheng, Z.; Qamar, S.A.; Chen, Z.; Mengiste, T. Arabidopsis WRKY33 transcription factor is required for resistance to necrotrophic fungal pathogens. Plant J. 2006, 48, 592–605. [Google Scholar] [CrossRef]
- Tang, J.; Wang, F.; Hou, X.L.; Wang, Z.; Huang, Z.N. Genome-Wide Fractionation and Identification of WRKY Transcription Factors in Chinese Cabbage (Brassica rapa ssp. pekinensis) Reveals Collinearity and Their Expression Patterns Under Abiotic and Biotic Stresses. Plant Mol. Biol Rep. 2014, 32, 781–795. [Google Scholar] [CrossRef]
- Zheng, Z.Y.; Mosher, S.L.; Fan, B.F.; Klessig, D.F.; Chen, Z.X. Functional analysis of Arabidopsis WRKY25 transcription factor in plant defense against Pseudomonas syringae. BMC Plant Biol. 2007, 7, 2. [Google Scholar] [CrossRef]
- Marchive, C.; Mzid, R.; Deluc, L.; Barrieu, F.; Pirrello, J.; Gauthier, A.; Corio-Costet, M.F.; Regad, F.; Cailleteau, B.; Hamdi, S.; et al. Isolation and characterization of a Vitis vinifera transcription factor, VvWRKY1, and its effect on responses to fungal pathogens in transgenic tobacco plants. J. Exp. Bot. 2007, 58, 1999–2010. [Google Scholar] [CrossRef]
- Liu, D.L.; Leib, K.; Zhao, P.Y.; Kogel, K.H.; Langen, G. Phylogenetic analysis of barley WRKY proteins and characterization of HvWRKY1 and -2 as repressors of the pathogen-inducible gene HvGER4c. Mol. Genet. Genomics. 2014, 289, 1331–1345. [Google Scholar] [CrossRef] [PubMed]
- Ramos, R.N.; Martin, G.B.; Pombo, M.A.; Rosli, H.G. WRKY22 and WRKY25 transcription factors are positive regulators of defense responses in Nicotiana benthamiana. Plant Mol. Biol. 2021, 105, 65–82. [Google Scholar] [CrossRef] [PubMed]
- Houterman, P.M.; Cornelissen, B.J.; Rep, M. Suppression of plant resistance gene-based immunity by a fungal effector. PLoS Pathog. 2008, 4, e1000061. [Google Scholar] [CrossRef] [PubMed]
- Hemetsberger, C.; Herrberger, C.; Zechmann, B.; Hillmer, M.; Doehlemann, G. The Ustilago maydis effector Pep1 suppresses plant immunity by inhibition of host peroxidase activity. PLoS Pathog. 2012, 8, e1002684. [Google Scholar] [CrossRef] [Green Version]
- Li, S.; Tang, Y.; Fang, X.; Qiao, T.; Han, S.; Zhu, T. Dermatomycosis caused by Arthrinium phaeospermum was first discovered in China–A new conditionally pathogenic fungus. Acta Mycol. Sin. 1990, 3, 232–235. [Google Scholar]
- Irieda, H.; Takano, Y. Identification and characterization of virulence-related effectors in the cucumber anthracnose fungus Colletotrichum orbiculare. Physiol. Mol. Plant Pathol. 2016, 95, 87–92. [Google Scholar] [CrossRef]
- Saitoh, H.; Fujisawa, S.; Mitsuoka, C.; Ito, A.; Hirabuchi, A.; Ikeda, K. Large-scale gene disruption in Magnaporthe oryzae identifies MC69, a secreted protein required for infection by monocot and dicot fungal pathogens. PLoS Pathog. 2012, 8, e1002711. [Google Scholar] [CrossRef] [Green Version]

| Sample | Raw Reads | Clean Reads | Effective Rate (%) | Q20 (%) | Q30 (%) | GC Content (%) |
|---|---|---|---|---|---|---|
| S1_1 | 54,580,508 | 51,965,959 | 95.21 | 98.19 | 94.55 | 53.41 |
| S1_2 | 55,019,871 | 53,176,919 | 96.65 | 98.2 | 94.55 | 53.76 |
| S1_3 | 53,461,164 | 51,508,083 | 96.35 | 98.12 | 94.28 | 53.49 |
| S2_1 | 51,674,777 | 49,164,128 | 95.14 | 98.5 | 95.38 | 53.92 |
| S2_2 | 54,082,748 | 52,079,582 | 96.3 | 98.52 | 95.38 | 53.94 |
| S2_3 | 52,537,865 | 50,166,387 | 95.49 | 98.49 | 95.33 | 53.78 |
| S3_1 | 52,623,574 | 50,656,315 | 96.26 | 98.56 | 95.53 | 54.41 |
| S3_2 | 50,987,904 | 48,749,504 | 95.61 | 98.52 | 95.41 | 54.22 |
| S3_3 | 52,046,192 | 49,929,476 | 95.93 | 98.59 | 95.58 | 54.16 |
| S4_1 | 50,341,624 | 48,424,820 | 96.19 | 98.73 | 95.94 | 54.58 |
| S4_2 | 55,324,267 | 52,522,315 | 94.94 | 98.46 | 95.21 | 54.52 |
| S4_3 | 48,067,887 | 45,606,368 | 94.88 | 98.79 | 96.08 | 54.48 |
| Sample | Total Reads | Total Mapped | Multiple Mapped | Uniquely Mapped |
|---|---|---|---|---|
| S1_1 | 148,594,824 | 4726 (0%) | 2591 (0%) | 2135 (0%) |
| S1_2 | 136,746,070 | 2489 (0%) | 1559 (0%) | 930 (0%) |
| S1_3 | 146,740,098 | 3722 (0%) | 2082 (0%) | 1640 (0%) |
| S2_1 | 126,643,902 | 7,306,133 (5.77%) | 23,757 (0.02%) | 7,282,376 (5.75%) |
| S2_2 | 137,144,488 | 7,537,105 (5.5%) | 28,209 (0.02%) | 7,508,896 (5.48%) |
| S2_3 | 132,487,818 | 6,700,653 (5.06%) | 23,231 (0.02%) | 6,677,422 (5.04%) |
| S3_1 | 169,973,228 | 38,580,876 (22.7%) | 136,813 (0.08%) | 38,444,063 (22.62%) |
| S3_2 | 126,157,938 | 29,676,163 (23.52%) | 118,045 (0.09%) | 29,558,118 (23.43%) |
| S3_3 | 132,852,916 | 32,475,890 (24.44%) | 124,742 (0.09%) | 32,351,148 (24.35%) |
| S4_1 | 120,447,454 | 60,467,620 (50.2%) | 139,444 (0.12%) | 60,328,176 (50.09%) |
| S4_2 | 106,076,392 | 51,212,956 (48.28%) | 118,143 (0.11%) | 51,094,813 (48.17%) |
| S4_3 | 167,634,532 | 82,155,824 (49.01%) | 169,114 (0.1%) | 81,986,710 (48.91%) |
| Sample | Total Reads | Total Mapped |
|---|---|---|
| S1_1 | 147,723,068 | 147,723,068 (74.11%) |
| S1_2 | 136,170,664 | 136,170,664 (74.35%) |
| S1_3 | 145,945,350 | 145,945,350 (74.99%) |
| S2_1 | 126,064,378 | 126,064,378 (71.50%) |
| S2_2 | 136,324,086 | 136,324,086 (72.18%) |
| S2_3 | 131,764,534 | 131,764,534 (72.98%) |
| S3_1 | 168,734,396 | 168,734,396 (58.43%) |
| S3_2 | 125,003,468 | 125,003,468 (58.29%) |
| S3_3 | 131,647,634 | 131,647,634 (57.61%) |
| S4_1 | 119,832,860 | 119,832,860 (36.16%) |
| S4_2 | 105,269,626 | 105,269,626 (37.57%) |
| S4_3 | 166,986,336 | 166,986,336 (36.77%) |
Publisher’s Note: MDPI stays neutral with regard to jurisdictional claims in published maps and institutional affiliations. |
© 2022 by the authors. Licensee MDPI, Basel, Switzerland. This article is an open access article distributed under the terms and conditions of the Creative Commons Attribution (CC BY) license (https://creativecommons.org/licenses/by/4.0/).
Share and Cite
Fang, X.; Yan, P.; Luo, F.; Han, S.; Lin, T.; Li, S.; Li, S.; Zhu, T. Functional Identification of Arthrinium phaeospermum Effectors Related to Bambusa pervariabilis × Dendrocalamopsis grandis Shoot Blight. Biomolecules 2022, 12, 1264. https://doi.org/10.3390/biom12091264
Fang X, Yan P, Luo F, Han S, Lin T, Li S, Li S, Zhu T. Functional Identification of Arthrinium phaeospermum Effectors Related to Bambusa pervariabilis × Dendrocalamopsis grandis Shoot Blight. Biomolecules. 2022; 12(9):1264. https://doi.org/10.3390/biom12091264
Chicago/Turabian StyleFang, Xinmei, Peng Yan, Fengying Luo, Shan Han, Tiantian Lin, Shuying Li, Shujiang Li, and Tianhui Zhu. 2022. "Functional Identification of Arthrinium phaeospermum Effectors Related to Bambusa pervariabilis × Dendrocalamopsis grandis Shoot Blight" Biomolecules 12, no. 9: 1264. https://doi.org/10.3390/biom12091264
APA StyleFang, X., Yan, P., Luo, F., Han, S., Lin, T., Li, S., Li, S., & Zhu, T. (2022). Functional Identification of Arthrinium phaeospermum Effectors Related to Bambusa pervariabilis × Dendrocalamopsis grandis Shoot Blight. Biomolecules, 12(9), 1264. https://doi.org/10.3390/biom12091264

